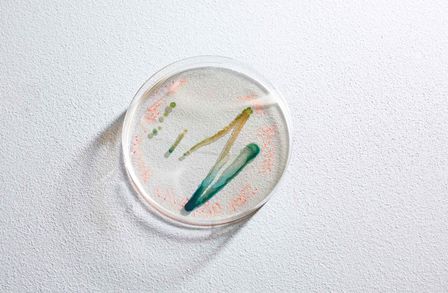

Issue 43
Imperial/43: Winter 2017–18
In Issue 43, we explore photosynthesis and uncover the mysterious chemistry of life on Earth. We also learn more about the potential for synthetic biology and hear from Imperial scientists Professor Neil Ferguson and Dr Nathalie MacDermott about fighting Ebola on the ground and in the lab.
There’s also all of our regular content, including a look one of Imperial’s student societies; an adventure in Life Sciences; and Our Imperial, where we talk to alumni Alex Bond, Chris Cieslak and Michelle Wong about how their experiences have inspired them to give back.
You can explore all the regular stories and features from Issue 43 on our website. You can also download Imperial Magazine issue 43 (PDF), or read the magazine online with Issuu.
In this issue
Features
Regulars
Imperative
Professor Franco Sassi on public policy
Society
Take the lunge with the Fencing Club
Disruptor
Dr Gerard Gorman on the transformation of software-writing for research
Our Imperial
Three alumni share how their experiences have inspired them to give back
Dataset
Professor Wendy Atkin and the groundbreaking cancer research that is saving money – and lives
Adventures in… Life Sciences
Professor Robert Ewers and the SAFE way to save rainforests
My Imperial
Fourth year Kunal Bhatia’s favourite spot – the Serpentine Bar & Kitchen